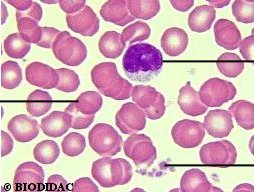

Complète le schéma
en faisant glisser les légendes.
Pour cela clique sur une légende, puis, sans relâcher le bouton
de la souris, fais glisser le mot jusque sur le schéma.
Les légendes doivent
être placées au bout des traits. Un message apparaît lorsque
toutes les légendes sont à la bonne place.